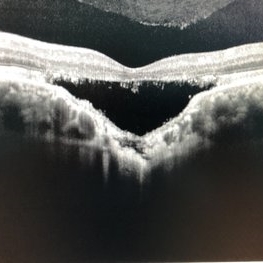

-
 Hamartoma Tuberous Sclerosis
Hamartoma Tuberous Sclerosis
Jun 2 2016 by Nelson Chamma Capelanes, MD
Fundus photograph of an 52-year-old man with tuberous sclerosis and retinal hamartoma.
Photographer: Nelson Chamma Capelanes, Fundação Hilton Rocha, Promédica Indaiatuba, Brazil
Condition/keywords: tuberous sclerosis
-
 Hamartoma Tuberous Sclerosis
Hamartoma Tuberous Sclerosis
Jun 7 2016 by Nelson Chamma Capelanes, MD
Fundus photograph of an 52-year-old man with tuberous sclerosis and retinal hamartoma.
Photographer: Nelson Chamma Capelanes, Fundação Hilton Rocha, Promédica Indaiatuba, Brazil
Imaging device: Heidelberg Spectralis
Condition/keywords: hamartoma, tuberous sclerosis
-
Retinal Dialysis (Superior) and Macula Off Detachment
Jan 23 2017 by Nelson Chamma Capelanes, MD
Retinal dialysis (superior) and macula off detachment after toxoplasmosis posterior uveitis.
Photographer: Nelson Chamma Capelanes, Promedica Indaiatuba
Condition/keywords: retinal dialysis
-
Retinal Dialysis (Superior) and Macula Off Detachment
Jan 23 2017 by Nelson Chamma Capelanes, MD
Retinal dialysis (superior) and macula off detachment after toxoplasmosis posterior uveitis.
Photographer: Nelson Chamma Capelanes, Promedica Indaiatuba
Condition/keywords: retinal dialysis
-
Retinal Dialysis (Superior) and Macula Off Detachment
Jan 23 2017 by Nelson Chamma Capelanes, MD
Retinal dialysis (superior) and macula off detachment after toxoplasmosis posterior uveitis.
Photographer: Nelson Chamma Capelanes, Promedica Indaiatuba
Condition/keywords: retinal dialysis
-
 Retained Perfluorcarbon and Macular Edema After Silicon Oil Removal
Retained Perfluorcarbon and Macular Edema After Silicon Oil Removal
Jul 24 2017 by Nelson Chamma Capelanes, MD
SD-OCT and HRA from a 42-year-old patient after silicon oil removal. The image shows macular edema and retained perfluorcarbon.
Photographer: Nelson Chamma Capelanes, Promedica Indaiatuba, Brazil
Condition/keywords: macular edema, post-vitrectomy, retained perfluorocarbon
-
 Retained Perfluorcarbon and Macular Edema After Silicon Oil Removal 3D
Retained Perfluorcarbon and Macular Edema After Silicon Oil Removal 3D
Jul 24 2017 by Nelson Chamma Capelanes, MD
SD-OCT and HRA from a 42-year-old patient after silicon oil removal. The image shows macular edema and retained perfluorcarbon.
Photographer: Nelson Chamma Capelanes, Promedica Indaiatuba, Brazil
Condition/keywords: macular edema, post-vitrectomy, retained perfluorocarbon
-
Choroidal Excavation
Choroidal Excavation
Jun 2 2019 by Nelson Chamma Capelanes, MD
SD-OCT of a 32-year-old woman showing a subfoveal choroidal excavation associated with chronic central serous chorioretinopathy.
Photographer: Nelson Chamma Capelanes, Promacula, Brazil
Imaging device: Heidelberg Spectralis SD-OCT
Condition/keywords: choroidal excavation, chronic central serous chorioretinopathy (CSCR), pachychoroid
-
 X-Linked Retinoschisis
X-Linked Retinoschisis
Nov 15 2019 by Nelson Chamma Capelanes, MD
SD-OCT of an 28-year-old man with X - linked retinoschisis.
Photographer: Nelson Capelanes, Promedica/Promacula Indaiatuba & UPO Oftalmologia São Paulo
Imaging device: Spectralis
Condition/keywords: x-linked retinoschisis (XLRS)
-
 X-Linked Retinoschis
X-Linked Retinoschis
Nov 15 2019 by Nelson Chamma Capelanes, MD
SD-OCT of an 28-year-old man with X - linked retinoschisis.
Photographer: Nelson Capelanes, Promedica/Promacula Indaiatuba & UPO Oftalmologia São Paulo
Imaging device: Spectralis
Condition/keywords: x-linked retinoschisis (XLRS)
-
 Intraocular Foreign Body
Intraocular Foreign Body
Jul 18 2022 by Nelson Chamma Capelanes, MD
Intraocular foreign body after stone trauma. Foreign body is found in the choroid. - Fundus image on the upper left: one day after the trauma showing subretinal and intraretinal hemorrhage - Fundus image on the upper right: 40 days after laser photocoagulation. - Lower left image: 30 days after the trauma, showing part of the foreign body in the nasal region. - Lower right image showing CT scan and intraocular foreign body location.
Photographer: Nelson Chamma Capelanes, Promacula Indaiatuba, Brazil
Imaging device: Canon CX-2
Condition/keywords: intraocular foreign body

A project from the American Society of Retina Specialists